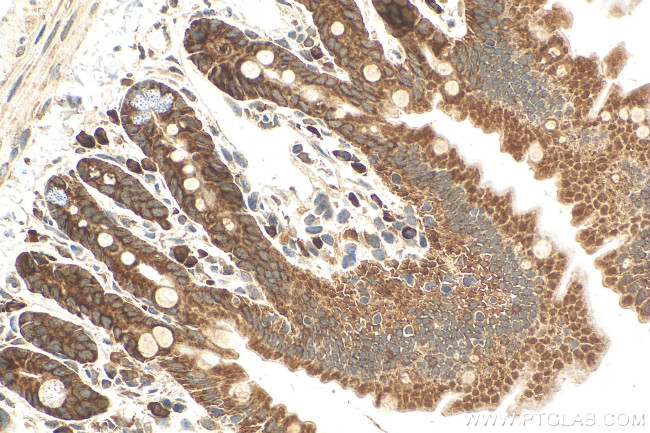
SETD3 Antibody in Immunohistochemistry (Paraffin) (IHC (P))

Search
Proteintech
SETD3 Polyclonal Antibody
{{$productOrderCtrl.translations['antibody.pdp.commerceCard.promotion.promotions']}}
{{$productOrderCtrl.translations['antibody.pdp.commerceCard.promotion.viewpromo']}}
{{$productOrderCtrl.translations['antibody.pdp.commerceCard.promotion.promocode']}}: {{promo.promoCode}} {{promo.promoTitle}} {{promo.promoDescription}}. {{$productOrderCtrl.translations['antibody.pdp.commerceCard.promotion.learnmore']}}
产品信息
28692-1-AP
种属反应
宿主/亚型
分类
类型
抗原
偶联物
形式
浓度
规格
纯化类型
保存液
内含物
保存条件
运输条件
产品详细信息
Immunogen sequence: MGKKSRVKTQ KSGTGATATV SPKEILNLTS ELLQKCSSPA PGPGKEWEEY VQIRTLVEKI RKKQKGLSVT FDGKREDYFP DLMKWASENG ASVEGFEMVN FKEEGFGLRA TRDIKAEELF
靶标信息
SETD3 is a histone methyltransferase that is involved in epigenetic transcriptional activation by methylating lysine residues on histone H3 tails.
仅用于科研。不用于诊断过程。未经明确授权不得转售。
篇参考文献 (0)
生物信息学
蛋白别名: Actin-histidine N-methyltransferase; Endothelial differentiation inhibitory protein D10; histone-lysine N-methyltransferase setd3; hSETD3; Protein-L-histidine N-tele-methyltransferase; SET domain containing 3, actin histidine methyltransferase; SET domain-containing protein 3; unnamed protein product
基因别名: 2610102I01Rik; 2610305M23Rik; 6030490B17Rik; C14orf154; D12Ertd771e; hSETD3; RGD1309550; SETD3
UniProt ID: (Human) Q86TU7, (Rat) G3V6U9, (Mouse) Q91WC0
Entrez Gene ID: (Human) 84193, (Rat) 299295, (Mouse) 52690